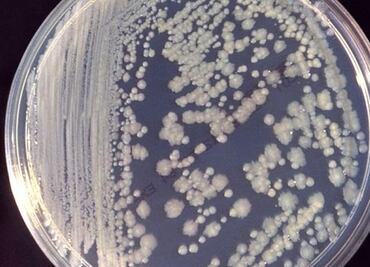
¿Bacterias en el espacio? Sí, también se adaptan para sobrevivir

NASA planea buscar microbios fuera de Estación Espacial Internacional; realizará segunda caminata espacial del año
La primera caminata este 2025 se llevó a cabo el jueves pasado

La primera caminata este 2025 se llevó a cabo el jueves pasado

Científicos del mundo entero impulsan el estudio de microorganismos con el potencial de revertir la acelerada degradación del planeta

Una joven mostró la diferencia entre bañarse a diario y no hacerlo.

Este procedimiento forma parte de la biología sintética

Según la investigación los microbios podrían sobrevivir durante millones de años

Los microorganismos estudiados poseían todavía sus funciones metabólicas al grado que podían reactivarse en un laboratorio

Investigadores han confirmado la ausencia de vida microbiana en algunas charcas saladas, calientes e hiperácidas del campo geotermal de Dallol, en Etiopía
La Estación Espacial Internacional alberga miles de microbios diferentes, que han viajado al espacio en astronautas o en la carga

Cerca del 70% de todos los microbios de la Tierra están bajo nuestros pies y algunos viven miles de años. Un proyecto en el que participan más de mil 200 científicos de 52 países estudian este ecosistema

Una investigación sugiere que una cantidad suficiente de hidrógeno podría ser producida mediante reacciones geoquímicas